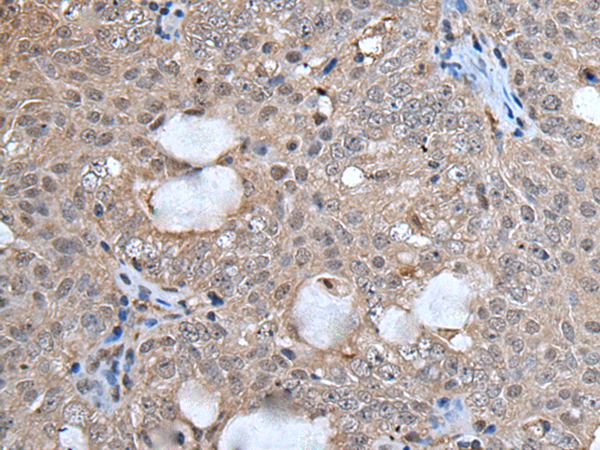

中文名稱: 兔抗UFM1多克隆抗體
|
Background: |
UFM1 is a ubiquitin-like protein that is conjugated to target proteins by E1-like activating enzyme UBA5 (UBE1DC1; MIM 610552) and E2-like conjugating enzyme UFC1 (MIM 610554) in a manner analogous to ubiquitylation (see UBE2M; MIM 603173) (Komatsu et al., 2004 [PubMed 15071506]). |
|
Applications: |
ELISA, IHC |
|
Name of antibody: |
UFM1 |
|
Immunogen: |
Full length fusion protein |
|
Full name: |
ubiquitin-fold modifier 1 |
|
Synonyms: |
BM-002; C13orf20 |
|
SwissProt: |
P61960 |
|
ELISA Recommended dilution: |
5000-10000 |
|
IHC positive control: |
Human ovarian cancer and human thyroid cancer |
|
IHC Recommend dilution: |
25-100 |
購物車
幫助
021-54845833/15800441009
